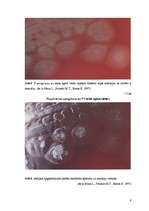
Referāts 'Pseudomoana aeruginosa mikroorganismu izolēšana no patoloģiskā materiāla un iden', 9.
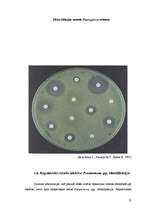
Referāts 'Pseudomoana aeruginosa mikroorganismu izolēšana no patoloģiskā materiāla un iden', 13.

-
Gēnu inženierija un selekcija
-
Gēnu inženierija un selekcija
AugstskolaReferāts6 -
Ģints "streptococcus" mikroorganismu izolēšana no patoloģiskā materiāla un id...
AugstskolaReferāts19 -
Pseudomoana aeruginosa mikroorganismu izolēšana no patoloģiskā materiāla un i...
AugstskolaReferāts16
Gēnu inženierija un selekcija
Faila izmērs:
7704 KB
Identifikators:
1144827